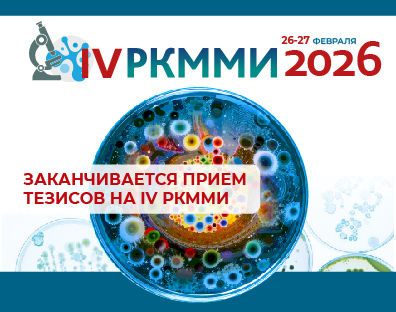

В ближайшее воскресенье, 18 января 2026 года, завершается прием тезисов на IV РКММИ. Заявки, поступившие позже, рассматриваться не будут.
После окончания срока подачи материалы передадут на рассмотрение Научному комитету. Комитет вправе отклонить работы после рецензирования. Материалы, оформленные с нарушениями, к печати не допускаются. Авторские права на статьи принадлежат их авторам.
Уведомления по итогам работы Научного комитета будут отправлены не позднее 26 января 2026 г.
Одобренные тезисы будут опубликованы в сборнике материалов к началу Конгресса.
С правилами и порядком оформления можно ознакомиться на сайте.
Подать тезисы необходимо через личный кабинет
После окончания срока подачи материалы передадут на рассмотрение Научному комитету. Комитет вправе отклонить работы после рецензирования. Материалы, оформленные с нарушениями, к печати не допускаются. Авторские права на статьи принадлежат их авторам.
Уведомления по итогам работы Научного комитета будут отправлены не позднее 26 января 2026 г.
Одобренные тезисы будут опубликованы в сборнике материалов к началу Конгресса.
С правилами и порядком оформления можно ознакомиться на сайте.
Подать тезисы необходимо через личный кабинет